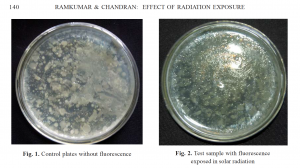

El próximo 12 de agosto alrededor de las 20:30 habrá un eclipse solar total en España. Comenzará así el trío de eclipses, porque habrá otros el 2 de agosto de 2027 y el 26 de enero de 2028. Nos vamos a aburrir de oír, leer y hablar del tema de los eclipses.
Un eclipse solar puede durar unas horas, pero la fase de oscuridad completa solo dura unos pocos minutos (depende mucho de la localidad).
Como no podía ser de otro modo, una de las preguntas que ya me han hecho es ¿cómo afectan los eclipses solares a las bacterias? La respuesta parece obvia: de ninguna manera.
Pero cuando uno busca en las bases de datos resulta que sí que hay gente que lo ha investigado: son solo tres artículos y curiosamente los tres de investigadores indios de la India.
Durante el eclipse aumenta la mortalidad bacteriana…
El primero de ellos se publicó en 1983 (Killing of bacteria during solar eclipse and its biological implications. Radiat Environ Biophys. 1983. 22(3):235-8). Lo que hicieron fue exponer a la bacteria Escherichia coli a la luz solar durante el eclipse del 16 de febrero de 1980 en Calcuta. El eclipse comenzó a las 14:47 y duró hasta las 17:00. El 96% de oscuridad fue a las 15:57. Compararon la supervivencia de la bacteria durante el eclipse y en un día normal (diez días después). Emplearon dos cepas de la bacteria: el control K12 y la cepa AB2480, un mutante muy sensible a la luz ultravioleta. Expusieron una concentración de 108 células/ml a la luz solar a distintos tiempos y midieron la supervivencia de la bacteria.
Los resultados demostraron que durante el eclipse solar aumentó la muerte de las bacterias debido a la radiación: mayor mortalidad bacteriana durante el eclipse, y las bacterias más sensibles a radiación ultravioleta murieron en mayor proporción. La conclusión de los autores fue que durante el eclipse llega más radiación ultravioleta de lo esperado, capaz de dañar el ADN bacteriano.
Puede parecer contraintuitivo: a menos luz, menos peligro. Si el Sol se tapa, llega menos luz y todo debería volverse más seguro. Menos luz, menos daño. Pero es al contrario. Durante un eclipse no solo cambia la cantidad de luz, sino su naturaleza. Y eso altera completamente las reglas del juego. Más oscuro, pero más energía. Aunque el brillo disminuye, aumenta el efecto de la radiación ultravioleta, la más peligrosa para las células. Es como si el Sol, antes de “apagarse”, dejara pasar justo la parte más dañina de su radiación. Para las bacterias, la radiación ultravioleta también es letal: daña directamente su ADN, causa mutaciones, impide que se reproduzcan y provocan su muerte.
Mirar al sol directamente sin protección durante el eclipse puede causar daños irreparables en la retina del ojo. Aunque las bacterias no tienen ojos, el aumento de radiación ultravioleta durante los momentos del eclipse también les daña y afecta a su supervivencia.
… y hay cambios en el fenotipo
Los otros dos artículos analizaron el efecto sobre las bacterias durante el eclipse solar del 15 de enero de 2010, que se observó también en la India. Los estudios se realizaron entre las 11:15 y las 15:15. En uno de ellos (Effect of radiation on bacterial population during annular solar eclipse. J Pure Appl Microbiol. 2011. 5(1):137-141) se expusieron cultivos de Escherichia coli en agua a diferentes fases del eclipse y midieron el número de bacterias vivas y los cambios en las colonias. Comprobaron una reducción entre un 51-63 % de las bacterias durante las horas pico del eclipse, lo que confirma los resultados del trabajo publicado en 1983.
Sin embargo, comprobaron que las poblaciones se recuperaban… e incluso podían crecer más que antes. ¿Por qué? Quizá el eclipse actúa como un filtro eliminando a los más débiles, dejando a las bacterias más resistentes, como si fuera un experimento exprés de selección natural.
Pero lo más curioso fue que las colonias de Escherichia coli en las placas de agar nutritivo desarrollaban fluorescencia tras su exposición a la radiación del eclipse solar.
Las colonias bacterianas obtenidas de las muestras expuestas a la radiación del eclipse, tras ser sembradas en medio de agar nutritivo, desarrollaron colonias fluorescentes. Fuente: referencia.
Según los autores, este fenómeno podría atribuirse a los efectos mutagénicos de la radiación producida durante el eclipse.
Otros autores (Effect of solar eclipse on microbes. J Pharm Bioallied Sci. 2011. 3(1):154-7), durante el mismo eclipse de 2010, analizaron el efecto en cultivos de las bacterias Staphylococcus aureus, Klebsiella y Escherichia coli, y sobre la levadura Candida albicans. Expusieron los cultivos a la luz solar durante el eclipse y a la luz solar normal en Mangalore (Karnataka, India). En este caso se analizaron los cambios morfológicos durante la exposición a la luz solar normal y la fase del eclipse. Se compararon las características de los cultivos y las reacciones bioquímicas, y se evaluaron las diferencias en la sensibilidad a los antibióticos. Los resultados sugieren que el eclipse no solo afecta a la supervivencia, sino también al comportamiento y a las características de los microorganismos. Se observó una tinción irregular en los cultivos expuestos durante el eclipse, lo que sugiere cambios en la morfología celular. Aunque no se observaron cambios en las reacciones bioquímicas, hubo una muy ligera variación en la sensibilidad a antibióticos: las bacterias durante el eclipse eran un poco más resistentes a los antibióticos. Quizá estos cambios fueron debidos a los efectos de la luz ultravioleta en el ADN.
Resultados difíciles de interpretar
Estos trabajos sugieren que durante el eclipse aumenta el impacto de la radiación ultravioleta lo que puede reducir temporalmente la viabilidad de las bacterias, puede inducir cambios mutagénicos que afecten a algunas propiedades de los microorganismos.
Sin embargo, los estudios sobre el efecto de los eclipses en el mundo microbiano son muy limitados y es muy arriesgado sacar conclusiones. En realidad la explicación de que durante el eclipse llega más radiación ultravioleta parece que no es correcta. Durante el mismo eclipse del 15 de enero de 2010 en India otros investigadores también midieron el efecto sobre la irradiancia solar directa. Comprobaron que la radiación ultravioleta disminuyó de forma muy acusada a medida que la Luna cubría el Sol. El mínimo se alcanzó cerca del máximo del eclipse, cuando la ocultación solar era mayor. Además, la reducción de la radiación fue selectiva según la longitud de onda: las longitudes de onda más cortas (más energéticas) disminuyeron más intensamente que las longitudes de onda más largas. Esto implica que durante el eclipse cambia la cantidad y calidad de la radiación ultravioleta. Resultados similares se obtuvieron en Bulgaria durante los eclipses del 11 de agosto de 1999 y del 29 de marzo de 2006.
En conclusión, no existe una evidencia robusta de que los eclipses solares alteren significativamente el crecimiento bacteriano, induzcan mutaciones específicas o cambien la dinámica poblacional de forma relevante. No hay replicaciones modernas en revistas de alto impacto y no es un campo activo de investigación
Pero, lo que las bacterias nos enseñan
Cuando el cielo se oscurece en pleno día y el Sol queda oculto tras la Luna, todos miramos hacia arriba. Es uno de los espectáculos más fascinantes de la naturaleza. Lo que nos enseñan las bacterias es que es muy peligroso mirar al sol durante el eclipse.
Durante un eclipse la luz ambiental disminuye y tus pupilas se dilatan. Aunque te parezca seguro mirar, las pupilas tan abiertas permiten que entre más radiación de golpe, y el daño puede ser aún mayor. El Sol sigue emitiendo radiación peligrosa incluso cuando está parcialmente cubierto por la Luna. Emite radiación ultravioleta e infrarroja muy intensa. La luz ultravioleta quema las células de la retina y la radiación infrarroja calienta y daña los tejidos del ojo, aunque no lo notes porque la retina no tiene receptores del dolor. El resultado puede ser una retinopatía solar, una lesión irreversible que causa puntos ciegos o pérdida permanente de visión.
Recuerda lo que nos enseñan las bacterias y el próximo 12 de agosto no mires directamente al sol, usa siempre gafas homologadas y diseñadas específicamente para la observación directa del Sol que permiten observar sin riesgo.

